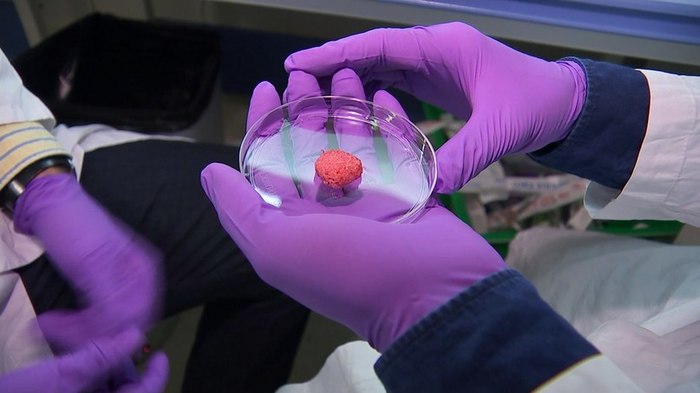

Хочешь выделиться? Верь в рептилоидов
Миллионы людей верят в разного рода конспирологические теории: от всеми любимой плоской Земли до правящего миром союза сионистов и рептилоидов. Но что объединяет всех приверженцев таких теорий, и почему люди вообще склонны верить в существование заговоров?
Перевод от проекта Newочём
Оригинал статьи: Aeon.
В интернете полно разного рода невероятных слухов. А может, случайные происшествия вовсе не случайны, и группа влиятельных заговорщиков вынашивает план захвата мира во имя некоего таинственного кукловода? Как отметил Карл Поппер в своей книге «Предположения и опровержения» (1963), некоторые люди склонны приписывать все, что их не устраивает, намеренным действиям влиятельных «других». Теории заговора существуют уже давно, а интернет только ускорил их распространение (как и распространение любой другой информации). Итак, кто же верит в теории заговора, и что у них может быть общего?
Конечно, в каждой теории есть своя доля правды. Согласно опросу 2013 года, каждый второй гражданин США убежден в том, что за убийством Джона Кеннеди в 1963 году стоит заговор. При этом «только» 4% утверждают, что «наш мир контролируют рептилоиды, принимающие облик человека и так зарабатывающие власть и влияние». ( Что страшно, в такое верит ни много ни мало 12 миллионов человек.)
Несмотря на эт и различия, одно из наиболее обоснованных исследований по теориям заговора гласит, что, несмотря на разнообразие теорий, у всех их последователей есть нечто общее. Например, люди, которые верят в рептилоидов, более склонны сомневаться, что Ли Харви Освальд действовал в одиночку. В самом деле, те, кто верит, что Усама бен Ладен умер еще до начала операции спецназа США, более склонны считать правдоподобной версию о том, что бен Ладен все еще жив. Это привело ученых к выводу, что вера в теории заговора зависит скорее не от конкретной темы, а от мировоззрения в общем. «Принятие идей теорий заговора», «однобокая система убеждений» или «конспиративное мировоззрение» можно считать признаками людей, убежденных, что миром управляют скрытые зловещие силы.
Большинство обвиняет конспиративное мировоззрение в том, что из-за него серьезно снижается ощущение контроля над жизнью, которой управляют случайности или интриги других. В рамках исследования одну группу участников попросили вспомнить моменты, когда они не контролировали ситуацию (например, при изменении погоды), а других моменты, когда контролировали (например, что надеть или где поесть). Первые были более склонны принять теорию заговора, чем вторые. Точно так же участники опроса, имеющие проблемы с трудоустройством и недостаток контроля в этой области (долгое время безработные или временно трудоустроенные), показывали более высокий уровень конспиративного мировоззрения, нежели обладающие контролем (постоянно трудоустроенные). Логическое объяснение кроется в том, что недостаток контроля заставляет искать замену, иллюзию контроля — и не где-нибудь, а в теориях заговора. Выявление закономерностей там, где их нет, по крайней мере дает возможность получения контроля, в то время как приписывание природного катаклизма неизменяемой и неконтролируемой погоде такой возможности не дает.
Но это еще не все. Такая теория компенсации выставляет верящих в заговоры бедными жертвами, у которых отняли контроль, и теперь они хватаются за теории как за соломинку, чтобы не утонуть в пучине мирового хаоса. Однако этому почти стереотипному образу противоречит вызывающее поведение настоящих одержимых теориями заговора, которые считают себя высшим разумом и называют всех, кто не с ними, несведущим стадом (в Германии для этого есть специальное слово Schlafschaf, дословно «спящие овцы»). Согласно наблюдениям, принятие теории заговора не обязательно является простой компенсацией недостатка контроля. Оно может означать и кое-что другое. С помощью веры в заговоры можно выделиться из невежественной толпы: это своего рода хвастовство собственными исключительными знаниями. То есть принятие теории заговора может являться не только результатом недостатка контроля, но и засевшей глубоко внутри потребностью быть не таким, как все. Наша исследовательская группа на практике проверила эту гипотезу при помощи серии экспериментов.
В ходе первого исследования обнаружилась закономерность между желанием людей быть особенными и их готовностью поверить в теории заговора. Более того, люди, склонные принимать теории заговора, зачастую верили теориям, которые сами по себе принимались очень небольшим количеством людей. Иными словами, обладающие конспиративным мировоззрением более склонны верить в менее популярные теории, полагая, что «исключительность» такой веры — это как раз то, что им нужно.
Конечно, зависимость не означает причинность (даже если события часто происходят вместе). Открытие того, что люди с сильной потребностью в уникальности чаще принимают теории заговора, может означать, что потребность заставляет их верить в теории, чтобы отделить себя от наивной толпы. Или это может означать, что вера в теории заговора увеличивает потребность ощущать себя особым и выдающимся, а вера — это способ отдалить себя от невежественных многих. А может, прямой связи и вовсе нет: возможно, люди, которых не волнует чужое мнение, показывают таким образом намерение отделить себя от остальных и их суждений. Мы решили провести эксперимент и поставить завершающую точку в вопросе причинно-следственных связей.
Мы придумали теорию заговора и попросили участников-американцев прочитать о несуществующих спорах, разворачивающихся в Германии. Согласно немецкому жилищному законодательству, в доме обязательно должен быть установлен индикатор дыма (это, кстати, правда). А вот дальше идет вымысел: якобы какой-то отставной инженер обнаружил, что эти индикаторы дыма испускают «гиперсигнал», вызывающий тошноту, гастрит и депрессию. Все эти обвинения яро отрицались компанией VdS Schadenverhütung GmbH, самым крупным (и вымышленным) производителем индикаторов дыма. Теория заговора звучит так: VdS и правительство в сговоре. В компании знают об опасных индикаторах и ничего не предпринимают. Одной группе испытуемых мы сказали, что в теорию верит большинство жителей Германии (81%), а другой, что меньшинство (19%). Согласно нашей гипотезе, обладающие более высоким уровнем конспиративного мировоззрения (уже соотнесенного с высокой потребностью в уникальности) более склонны поверить в заговор, если теорию принимают немногие, и наоборот. Именно это и показали результаты нашего эксперимента. Теория представлялась более привлекательной, если в нее верило меньшинство. Ведь это отличный способ выделиться из толпы.
Эти открытия нарисовали более детальную картину того, что привлекает людей в теориях заговора. И хотя результаты нашего эксперимента с индикаторами дыма были относительно скромны, они обоснованы. Во Франции независимая группа проверяла ту же самую гипотезу (об экспериментах друг друга мы не знали) и получила результат, очень близкий к нашему. Видение злобных заговоров за практически каждым мировым событием — это не только попытка найти в мире смысл. Оно также может быть довольно полезным само по себе, ведь предоставляет исключительное знание, которое выделяет нас из стада спящих овец.
Автор: Роланд Имхофф.
Другие переводы зарубежных СМИ от Newoчём здесь